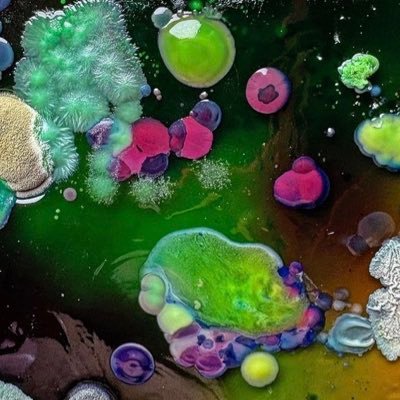

baby✰panic! @ccxsharp
in a lava lamp inside my brain hotel detroit Joined July 2011-
Tweets4K
-
Followers509
-
Following231
-
Likes7K
been rolling 1’s & 3’s my whole life. this next one’s a 6.
0
0
0
16
0
yo bitch when she seen these sketchers light up
yo bitch when she seen these sketchers light up
baby✰panic! retweeted
The crazy thing about the devil if he can’t get to you he will go for everything around you stay prayed up & keep fighting.
w mans

emi | 18+ | mdni @headlikahole
26K Followers 5K Following 18+ | mdni | dedicated bill skarsgård fan | 23 | she/her/they/them | ig: emileighxrose
WALTER ANDRES CORDOBA... @walter_gar39626
0 Followers 28 Following
jayduh @Ohno_itsjayda
408 Followers 8 Following i am your leader https://t.co/77QvhW05qV don’t dm me anywhere
julia payton @julia_payt0n
94 Followers 30 Following
Teteni @teteni54970
26 Followers 2K Following I hope that I will be mature and stable and survive the desperate situation and live a better life.
low battery @momjeangood_
0 Followers 22 Following my life can only be expressed through Midwestern emo revival playlists
𓃓 @lumdsey
15K Followers 751 Following 26 • they/them • reiki practitioner • EDS POTS MCAS • 21+ @ochampionmine @veilbuilt @thefairygami • $10 dm fee $lumdsey
Jasminejanay @Jasminejanay8
10 Followers 81 Following
PrettyGrittyEBM @PrettyPGE
151 Followers 296 Following Pretty Gritty Eastbaymud (P.G.E.) Snap: EastBayMud
Jackiefairchild @Jackifairchild
0 Followers 33 Following
Mal @mallorysmolensk
82 Followers 412 Following I’m slowly trying to fall in love with myself 🤍 05.02.20 🌼
mmm @Mallory29132946
1 Followers 2 Following
lea @_leamiller
554 Followers 319 Following
da_real_stevie_wonder @DaSteveie
3 Followers 42 Following I’m blind and love soul, pop, rhythm and blues, junk and jazz
Lee Zimmerman 🌊 @zim2918
76K Followers 75K Following SPIN Distinguished Silk Artist, PhD, all artwork presented here is my own. PLEASE FOLLOW ME AT Blue Sky at zim2918
bimbo baggins @allyson_meghan
3K Followers 966 Following what on earth would we do without one another 🇵🇸
ODM Riq @ODM_Riq
285 Followers 296 Following I Spit the Heat 🗣🔥💯 I Make Da Beatz 🖥🎧🎹 Straight Outa Queenz 📍💸💳Videos Comin Soon 📷https://t.co/S763rsgcXo
kim @justsaycanoe
239 Followers 370 Following i tried to tell all my friends when i was a kid that i had powers and nobody wanted to believe me
tyler 🌀 @tyler_Lite
225 Followers 270 Following
perfect_feet_in_sexy_... @foiledcranium
257 Followers 896 Following “Hi there” - Peter Gabriel, Big Time (1986)
m @sus2chainz
8K Followers 708 Following
💚 goupbrain 💚 @goupbrain
9K Followers 891 Following Instagram: goupbrain // I have a bigger dick than u// art // 18+ ❗️
. @user1234666666
2K Followers 1K Following![[...]the aura of my inner demons like an analog photo of the reflection of myself on a Sunday night at 3am after I finished my second bottle of wine](https://pbs.twimg.com/profile_images/1207037241245212672/UTkaGFL6.jpg)
alexandra vinter @al_wxvinter
71 Followers 396 Following [...]the aura of my inner demons like an analog photo of the reflection of myself on a Sunday night at 3am after I finished my second bottle of wine
emi | 18+ | mdni @headlikahole
26K Followers 5K Following 18+ | mdni | dedicated bill skarsgård fan | 23 | she/her/they/them | ig: emileighxrose
jayduh @Ohno_itsjayda
408 Followers 8 Following i am your leader https://t.co/77QvhW05qV don’t dm me anywhere
julia payton @julia_payt0n
94 Followers 30 Following
lucki lyrics bot @LUCKI_BOT
640 Followers 10 Following lucki lyrics bot, all credit to @FLAWLESSLUCKI
𓃓 @lumdsey
15K Followers 751 Following 26 • they/them • reiki practitioner • EDS POTS MCAS • 21+ @ochampionmine @veilbuilt @thefairygami • $10 dm fee $lumdsey
Jasminejanay @Jasminejanay8
10 Followers 81 Following
PrettyGrittyEBM @PrettyPGE
151 Followers 296 Following Pretty Gritty Eastbaymud (P.G.E.) Snap: EastBayMud
Mal @mallorysmolensk
82 Followers 412 Following I’m slowly trying to fall in love with myself 🤍 05.02.20 🌼
lea @_leamiller
554 Followers 319 Following
Lee Zimmerman 🌊 @zim2918
76K Followers 75K Following SPIN Distinguished Silk Artist, PhD, all artwork presented here is my own. PLEASE FOLLOW ME AT Blue Sky at zim2918
yvette young @youyve
41K Followers 595 Following guitars/riff crafter in @covettheband. Piano and violin and singing sometimes 🐦 full time clown [email protected]
bimbo baggins @allyson_meghan
3K Followers 966 Following what on earth would we do without one another 🇵🇸
ODM Riq @ODM_Riq
285 Followers 296 Following I Spit the Heat 🗣🔥💯 I Make Da Beatz 🖥🎧🎹 Straight Outa Queenz 📍💸💳Videos Comin Soon 📷https://t.co/S763rsgcXo
kim @justsaycanoe
239 Followers 370 Following i tried to tell all my friends when i was a kid that i had powers and nobody wanted to believe me
tyler 🌀 @tyler_Lite
225 Followers 270 Following
perfect_feet_in_sexy_... @foiledcranium
257 Followers 896 Following “Hi there” - Peter Gabriel, Big Time (1986)
m @sus2chainz
8K Followers 708 Following
💚 goupbrain 💚 @goupbrain
9K Followers 891 Following Instagram: goupbrain // I have a bigger dick than u// art // 18+ ❗️
. @user1234666666
2K Followers 1K Following![[...]the aura of my inner demons like an analog photo of the reflection of myself on a Sunday night at 3am after I finished my second bottle of wine](https://pbs.twimg.com/profile_images/1207037241245212672/UTkaGFL6.jpg)
alexandra vinter @al_wxvinter
71 Followers 396 Following [...]the aura of my inner demons like an analog photo of the reflection of myself on a Sunday night at 3am after I finished my second bottle of wine
No recent Favorites. New Favorites will appear here.
Trends for United States
77,4 B posts
21,5 B posts
8.185 posts
11,1 B posts
23,2 B posts
141 B posts
7.678 posts
1.253 posts
10,9 B posts
8.207 posts
9.400 posts
1.105 posts
2.068 posts
7.515 posts
59,4 B posts
69,5 B posts
33,7 B posts